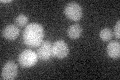
YNR027W
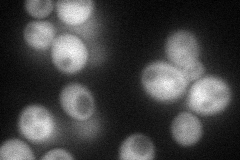
YNR027W
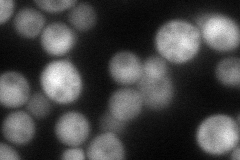
YNR027W
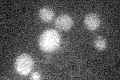
YNR027W

View description
Putative pyridoxal kinase, a key enzyme in vitamin B6 metabolism; involved in bud-site selection; diploid mutants display a random rather than a bipolar budding pattern; similarity to yeast BUD16 and human pyridoxal kinase (PDXK)
Localization:
Intensity:
Fold change:
Significance:
-
C’ GFP library in SD
below threshold15.64 -
N' NOP1pr-GFP in SD
cytosol67.6403 -
N' TEF2pr-mCherry in SD
cytosol95.9141 -
N' NATIVEpr-GFP in SD

below threshold23.8768 -
N' TEF2pr-VC and Cyto-VN in SD

#N/A0 -
C’ GFP library in SD+DTT

cytosol16.861.07No -
C’ GFP library in SD+H2O2

cytosol16.531.05No -
C’ GFP library in Starvation Media
cytosol17.541.12No -
C’ GFP library on the background of Pup2-DaMP

below threshold -
C’ GFP library on the background of CCT mutant

below threshold17.73631.13344No
